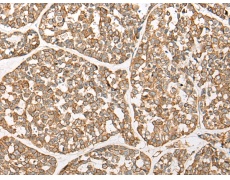
一抗

|
Background: |
The protein encoded by this gene is a member of the fibroblast growth factor (FGF) family. FGF family members possess broad mitogenic and cell survival activities and are involved in a variety of biological processes including embryonic development, cell growth, morphogenesis, tissue repair, tumor growth and invasion. This gene was identified by its similarity with mouse fgf3/int-2, a proto-oncogene activated in virally induced mammary tumors in the mouse. Frequent amplification of this gene has been found in human tumors, which may be important for neoplastic transformation and tumor progression. Studies of the similar genes in mouse and chicken suggested the role in inner ear formation. |
|
Applications: |
ELISA, WB, IHC |
|
Name of antibody: |
FGF3 |
|
Immunogen: |
Synthetic peptide of human FGF3 |
|
Full name: |
fibroblast growth factor 3 |
|
Synonyms: |
INT2; HBGF-3 |
|
SwissProt: |
P11487 |
|
ELISA Recommended dilution: |
5000-10000 |
|
IHC positive control: |
Human liver cancer and human esophagus cancer |
|
IHC Recommend dilution: |
25-100 |
|
WB Predicted band size: |
27 kDa |
|
WB Positive control: |
Rat liver tissue lysate |
|
WB Recommended dilution: |
200-1000 |



 購物車
購物車 幫助
幫助
 021-54845833/15800441009
021-54845833/15800441009